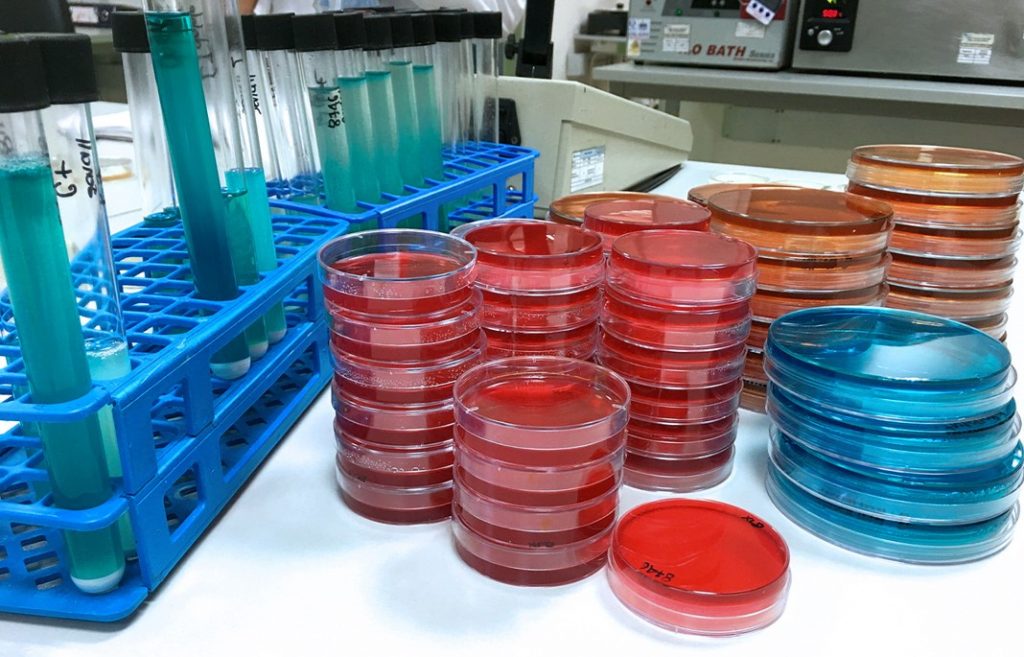

Laboratorio de Ensayos
Aguas
Se realiza análisis:
- AGUA DE USO Y CONSUMO HUMANO
- Agua envasada
- Agua potable
- Agua de piscinas
- AGUA NATURAL
- Agua subterránea
- Agua superficial
- AGUA RESIDUAL
- Agua residual doméstica
- Agua residual industrial
- AGUA SALINA
- Agua de mar
- AGUA DE PROCESO
- Agua purificada

Aire y Superficies
Análisis Microbiológico:
- Aire
- Superficies viva de Manipulador de alimentos
- Superficies inertes en contacto con alimentos
Análisis Microbiológicos
- Productos cárnicos: Carne cruda, embutidos, etc.
- Productos lácteos: Leche cruda, evaporada, en polvo, etc.
- Productos de panadería y pastelería: Pan , galletas, panetón, keke
- Alimentos preparados.
- Productos de confitería
- Azúcares, mieles y derivados.
- Productos grasos
- Conservas
- Ovoproductos

¿En qué te ayudamos?
Envíanos tus consultas. Nos encargaremos de comunicarnos para brindarte todo nuestro apoyo y nuestro mejor servicio.